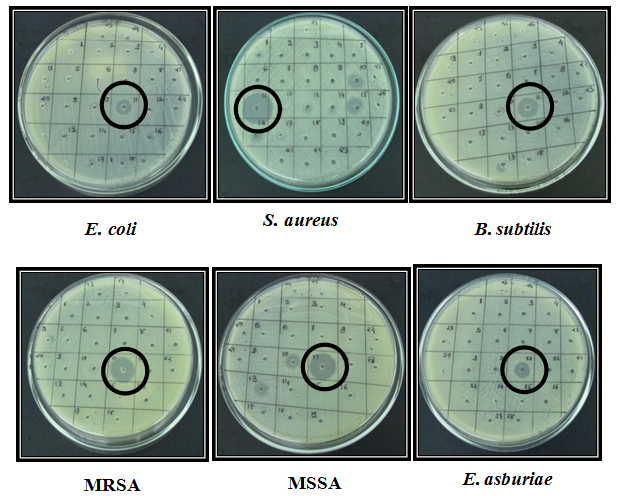

*1Ashok & Rita Patel Institute of Integrated Study & Research In Biotechnology And Allied Sciences (ARIBAS), New V V Nagar, Gujarat. India, 2Smt. L P Patel Institute Of Medical Laboratory Tech, Charutar Arogya Mandal, Karamsad Gujarat. India.
Email: devjani.chakraborty@yahoo.com
Received: 10 Dec 2014 Revised and Accepted: 01 Jan 2015
ABSTRACT
Objective: The aim of the present study was to isolate an antimicrobial peptide from heart tissue of Capra hircus (Goat) and to check its antibacterial activity against antibiotic resistant and antibiotic sensitive bacterial strains.
Methods: Total protein was extracted from heart tissue of goat using extraction buffer, purified by cation exchange column chromatography and tested in vitro for antibacterial activity against MTCC bacterial strains as well as clinical isolates using the agar well diffusion method. MIC was also checked by microbroth dilution method. Mass spectrometry was performed for partially purified protein fraction.
Results: The present work revealed that crude protein extracted from the heart tissue of goat was found to have antimicrobial activity. Partially purified protein fraction also showed the zone of inhibition and MIC value against all the bacteria tested. Mass spectrometry data showed the molecular weight of the peptide to be ~6.5 kD along with peptide to be present in the oligomeric form.
Conclusion: The present study showed that the defens in is an antimicrobial peptide with broad range of effect which is present in dimer, trimer and oligomeric form.
Keywords: Antimicrobial peptide (AMPs), Capra hircus (Goat), Defensin, Mass spectrometry, Oligomerization.
INTRODUCTION
β – Defensin falls in the category of antimicrobial peptides (AMPs) considered being the most important feature of the innate immune system. AMPs are short stretches of amino acids with low molecular weight, usually ranging between a dipeptide of 2 amino acids to a short peptide of 50 amino acids with large content of positively charged amino acid residues such as arginine (R) and lysine (K). These positively charged residues provide overall positive charge to the peptide at physiological pH and helps in interaction with negatively charged bacterial cell membrane[1]. The parameters which are essential for the antimicrobial activity of an antimicrobial peptide include its amino acid sequence, charge, secondary structure, amphipathicity and hydrophobicity. Different models have been proposed for their mode of action. All these models assume that the AMPs get aggregated at the site of bacterial infection in the membrane bound state[2]. Antimicrobial peptides are able to kill microbes but remain nontoxic to mammalian cells. This is due to difference in lipid composition between prokaryotic and eukaryotic cell membrane. A less negative membrane potential in eukaryotes than prokaryotes also play an important role in the selectivity of cells by AMPs.
Defensins are cysteine rich cationic peptides within 20-40 amino acids residues having 4-12 KDa molecular weight. They are found in vertebrates, invertebrates as well as in plants. The six cysteine residues in the structure of defensins form three disulphide bonds. Defensins are also called as corticostatins because some of them inhibit corticotropin stimulated corticosteroid production[3]. Defensins kill gram positive as well as gram negative bacteria. They also act on fungi. Some defensins are able to neutralize herpes simplex virus and influenza virus[4]. Mammalian defensins are divided into three super-families depending on their structure and distribution. They are α defensins, β defensins and θ defensins.
The rationale behind the discovery of AMPs is the development of antibiotic resistance against conventional antibiotics by many of the pathogenic microorganisms. So AMPs are recognized as a new family of antibiotics that have stimulated research in the field of discovery of new AMPs or combinations of AMP-Antibiotic remedies and their application as new therapeutic agents against many infectious and disease causing multi-drug resistance bacteria[5]. In the present experiment, we have isolated and characterized β defensin from heart tissue of the Goat (Capra hircus) and have checked its efficacy on few antibiotic sensitive and resistant bacteria.
MATERIALS AND METHODS
Sample collection and processing
Fresh heart tissue (ventricles) of the Goat (Capra hircus) was obtained from the registered slaughter house, Anand district, Gujarat. It was transported to the laboratory in capped container maintaining 4°C temperature. In the laboratory, heart tissue was blotted free of blood, cut into pieces and known amount of heart tissue was grinded in pre-chilled mortar-pestle using protein extraction buffer[6]. Extracted protein was lyophilized and stored at -20°C until further processing.
Crude protein extract profile
The crude protein isolated from heart tissue was further subjected to one dimensional sodium dodecyl sulphate polyacrylamide gel electrophoresis (1-D SDS PAGE). Protocol for 1-D SDS PAGE was designed for vertical slab gel electrophoresis (Biorad-Mini Protean Tetra cell). 15% polyacrylamide gel was prepared. After completion of the run, the gels were processed for standard Coomassie blue staining and the bands obtained were visualized using gel doc (Gelstan).
Purification of crude protein
Purification of crude protein was carried out using cation exchange column chromatography. Initially crude protein was precipitated using acetone (1: 4; protein: acetone), obtained pellet was re-dissolved in 0.2 M NaCl, prepared in 50 mM sodium phosphate buffer (pH 7.0) and loaded onto Macroprep High S Cation Exchanger Column (Biorad). Elution was performed with a linear gradient of 0.2 to 1.0 M NaCl prepared in 50 mM sodium phosphate buffer with pH gradient starting from 3 to 8 with flow rate 1 ml/min. The partially purified fractions eluted from the column were observed at 280 nm on nanodrop (Thermo scientific).
Antibiotic sensitive and antibiotic resistant bacterial strains
Total 10 bacterial strains were used for the following study. 5 bacterial strains (QC), Escherichia coli (MTCC no. 443), Enterococcus fecalis (MTCC no. 439), Pseudomonas aeruginosa (MTCC no. 741), Staphylococcus aureus (MTCC no. 740), Bacillus subtilis (MTCC no. 2423), were obtained from the Microbial Type Culture Collection (MTCC), Chandigarh, India. Remaining 5 bacterial strains were clinical isolates obtained from various biological and non-biological sources, i. e. Methicillin Resistant Staphylococcus aureus (MRSA), Methicillin Sensitive Staphylococcus aureus (MSSA), Extended Spectrum Beta Lactamases (ESBL) and Enterobacter hormaechei and Enterobacter asburiae. The clinical isolates were confirmed by 16SrDNA sequencing. All these bacterial isolates were checked for antibiotic sensitivity testing (AST) following CLSI guidelines[7]. The antibiotics used in the present study were as follows, Ampicillin (10 µg/disc), Penicillin (10 units/disc), Cefoxitin (30 µg/disc), Tetracycline (30 µg/disc), Streptomycin (10 µg/disc) and Vancomycin (30 µg/disc).
Antimicrobial activity of protein fractions
Antimicrobial activity of crude protein extract as well as partially purified protein fractions, obtained from cation exchange column chromatography was studied. It was performed using agar well diffusion method on 2% Mueller Hinton agar (MHA). Cultures equivalent to 0.5 Mc Farland standard were spread on MHA plates using sterile viscous swabs. Wells was prepared using sterile cork borer, i. e. 6 mm wells were prepared for checking antimicrobial activity of crude protein extract while 3 mm well were prepared for checking antimicrobial activity of partially purified fractions. 100 µl of crude fraction and 5 µl of partially purified fractions were loaded into respective wells. Plates were incubated at 370C for 24 hrs. Partially purified protein fractions which showed antimicrobial activity against bacterial isolates were further analyzed for 1-D SDS PAGE and were applied to mass spectrometer (LCQ Fleet Ion Trap Mass Spectrometer, Thermo Scientific) for revealing the molecular weight of the isolated antimicrobial peptide. The data obtained were later scrutinized using Bioworks software and Sequest database.
Minimum inhibitory concentration (MIC) of the peptide
The MIC of the protein fraction was determined by micro broth dilution method. The value of MIC was confirmed at the peptide concentration which inhibits the bacterial growth. The working solution of crude protein extract (500 μg/mL) was diluted serially to give final testing concentrations of 500, 250, 125, 12.5, 62.25, 31.25, 15.62 and 7.81 μg/mL. The same procedure was followed for isolated protein fractions with the initial concentration of 100 μg/mL with subsequent dilution to the final testing concentrations of 50, 25, 12.5, 6.25, 3.12 and 1.56 μg/ml.
RESULTS
Profiling of crude protein extract
Fig. 1 explains the 1-D SDS PAGE profiling of crude protein extract isolated from the ventricles of heart tissue of the Goat (Capra hircus). In fig. 1, H denotes the total protein obtained from the heart tissue and M denotes the protein molecular weight marker used. The protein band pattern on polyacrylamide gel revealed the presence of a wide array of proteins having different molecular weight, i. e. Starting from 245 kD to less than 11 kD in the heart tissue.

Fig. 1: 1-D SDS PAGE Profile of crude protein fraction of heart
Antimicrobial susceptibility testing (AST)
AST of all the 10 bacterial strains (MTCC as well as clinical isolates) showed that all the MTCC bacterial strains were susceptible to the beta lactam antibiotics as well as to streptomycin, tetracycline and vancomycin. On the other hand clinical isolates showed the different degree of resistance to the antibiotics against which they were tested (table 1). The data obtained (zone of inhibition in mm) was compared with the standards of CLSI guidelines to confirm the sensitive and resistant behaviour. The idea behind selecting these antibiotics was to screen the bacterial strains against different classes of antibiotics, i.e. Ampicillin, penicillin and cefoxitin belonging to the group of beta lactam antibiotics, streptomycin is an aminoglycosides drug, tetracycline is a broad spectrum polyketide antibiotic and vancomycin is a glycopeptide antibiotic.
Table 1: Antimicrobial susceptibility testing of bacterial strains (CLSI Guideline)
Antibiotic Bacteria |
Ampicillin |
Penicillin |
Cefoxitin |
Streptomycin |
Tetracycline |
Vancomycin |
||||||
Zone of Inhibition (mm) |
||||||||||||
Obs. |
Concl. |
Obs. |
Concl. |
Obs. |
Concl. |
Obs. |
Concl. |
Obs. |
Concl. |
Obs. |
Concl. |
|
E. coli |
22.4 + 0.15 |
S |
24.6 + 0.15 |
S |
34.4 + 0.15 |
S |
28 + 0.2 |
S |
27 + 0.2 |
S |
21 + 0.12 |
S |
E. fecalis |
27 + 0.2 |
S |
23 + 0.2 |
S |
14 + 0.2 |
S |
11.4 + 0.25 |
S |
16.4 + 0.25 |
S |
24.6 + 0.15 |
S |
P. aeruginosa |
17.8 + 0.12 |
S |
23.2 + 0.12 |
S |
26 + 0.2 |
S |
21 + 0.12 |
S |
14.6 + 0.25 |
S |
24.6 + 0.15 |
S |
S. aureus |
22 + 0.12 |
S |
28 + 0.2 |
S |
30.2 + 0.12 |
S |
22.2 + 0.12 |
S |
37.2 + 0.41 |
S |
25.6 + 0.15 |
S |
B. subtilis |
18.6 + 0.15 |
- |
17.2 + 0.23 |
- |
24.6 + 0.15 |
- |
21.2 + 0.12 |
- |
23.2 + 0.12 |
- |
17.8 + 0.12 |
- |
MRSA |
9.8 + 0.12 |
R |
9 + 0.2 |
R |
14.8 + 0.30 |
R |
17.2 + 0.12 |
I |
27 + 0.2 |
I |
17.8 + 0.12 |
I |
MSSA |
34.4 + 0.15 |
S |
37.2 + 0.41 |
S |
30.4 + 0.15 |
S |
11.6 + 0.15 |
R |
22.2 + 0.12 |
S |
13.6 + 0.25 |
R |
ESBL |
0 |
R |
0 |
R |
20.2 + 0.12 |
S |
17.8 + 0.12 |
- |
21 + 0.28 |
- |
0 |
- |
E. hormaechei |
14 + 0.2 |
- |
0 |
R |
0 |
R |
15.2 + 0.12 |
- |
29.2 + 0.12 |
- |
9 + 0.2 |
- |
E. asburiae |
26 + 0.2 |
- |
0 |
R |
0 |
R |
23.2 + 0.12 |
- |
0 |
R |
10.4 + 0.15 |
R |
Values are represented: Avg + SEM: n=5
Obs. = Observed value, Concl.= Conclusion; R=Resistant, I=Intermediate, S = Sensitive, (- )= not available,
= MTCC Strains,
= Clinical isolates
Antimicrobial activity of protein/peptides
Crude peptides (CPH)
Antimicrobial activity of crude protein fractions showed significant zone of inhibition on MHA plates (fig. 2). Zone of inhibition (mm) was measured for all the bacteria. Tetracycline antibiotic (30 µg/ml) was used as positive control. As seen in table 2, the crude protein showed antimicrobial activity against all the bacteria except extended spectrum beta lactamase (ESBL).
Isolated peptides (LVF2)
Basically antimicrobial peptides are cationic in nature[8]. Therefore cation exchange column chromatography was adopted for the separation of positively charged protein/peptide from crude protein extract. Partially purified protein fractions were also tested for the antimicrobial activity using the method described previously. After incubation, zone of inhibition was observed against 6 bacterial isolates.
Fig. 2: Plates showing antimicrobial activity of LVF2
The fraction was labelled as LVF2 (Left Ventricle Fraction 2) which was eluted using 0.2 M NaCl prepared in phosphate buffer (pH 7.0). table 3 shows the zone of inhibition (mm) observed due to the antimicrobial activity of partially purified fraction. Antimicrobial activity was observed against 6 bacteria except ESBL, E. fecalis and P. aeruginosa. fig. 2 shows the zone of inhibition that was observed on MHA plates, which confirm the antimicrobial activity of the partially purified protein fraction (LVF2). Table 4 explains the MIC data of the crude and isolated peptide fraction.

Fig. 3: 1-D SDS PAGE of LVF2
Table 2: Antimicrobial activity of crude protein, CPH (Well Diffusion Method)
| S. No. | Bacteria | Gram type | Fractions | Zone diameter | Remark |
| 1. | E. coli | Gm –ve | Tetracycline | 30.6 + 0.17 mm | |
| 2. | CPH | 14.8 + 0.37 mm | Bacteria was sensitive to crude protein Fraction | ||
| 3. | E. fecalis | Gm +ve | Tetracycline | 25.0 + 0.14 mm | |
| 4. | CPH | 16.5+ 0.22 mm | Bacteria was sensitive to crude protein Fraction | ||
| 5. | P. aeruginosa | Gm –ve | Tetracycline | 22.4 + 0.17 mm | |
| 6. | CPH | 0 mm | Bacteria was resistant to crude protein Fraction | ||
| 7. | S. aureus | Gm +ve | Tetracycline | 37.4 + 0.17 mm | |
| 8. | CPH | 16.4 + 0.24 mm | Bacteria was sensitive to crude protein Fraction | ||
| 9. | Bacillus subtilis | Gm +ve | Tetracycline | 26.0 + 0.24 mm | |
| 10. | CPH | 12.4 + 0.24 mm | Bacteria was sensitive to crude protein Fraction | ||
| 11. | MRSA | Gm +ve | Tetracycline | 26.0 + 0.24 mm | |
| 12. | CPH | 18.4 + 0.24 mm | Bacteria was sensitive to crude protein Fraction | ||
| 13. | MSSA | Gm +ve | Tetracycline R | 0 mm | |
| 14. | CPH | 15.4 + 0.24 mm | Bacteria was sensitive to crude protein Fraction | ||
| 15. | ESBL | Gm –ve | Tetracycline | 22.0 + 0.24 mm | |
| 16. | CPH | 0 mm | Bacteria were resistant to crude protein Fraction | ||
| 17. | E. hormaechei | Gm –ve | Tetracycline | 18.6 + 0.17 mm | |
| 18. | CPH | 14.6 + 0.24 mm | Bacteria was sensitive to crude protein Fraction | ||
| 19. | E. asburiae | Gm +ve | Tetracycline | 22.4 + 0.17 mm | |
| 20. | CPH | 11.6 + 0.24 mm | Bacteria was sensitive to crude protein Fraction |
Tetracycline=Control Antibiotic CPH= Crude Protein of Heart
Table 3: Antimicrobial activity of isolated column eluted fractions, LVF2 (Well Diffusion Method)
| S. No. | Bacteria | Zone of inhibition (mm) Heart tissue (LVF2) Left ventricle (0.2 M NaCl in Phosphate buffer, pH: 7) |
| 1. | E. coli | 10 mm |
| 2. | E. fecalis | 18 mm |
| 3. | P. aeruginosa | 0 mm |
| 4. | S. aureus | 18 mm |
| 5. | B. subtilis | 11 mm |
| 6. | MRSA | 15 mm |
| 7. | MSSA | 15 mm |
| 8. | ESBL | 0 mm |
| 9. | E. hormaechei | 0 mm |
| 10. | E. asburiae | 12 mm |
Mass spectrometric analysis
The Biowork data revealed the column eluted fraction of Heart tissue (LVF2) showed molecular weight of 6540 D (6.5 kD) (fig. 4). Other peaks showing molecular weight of 13080 D (13 kD) and 19793 D (19.7 kD) were also observed. By studying the mass spectra and analyzing with Sequest databases, it was confirmed that the isolated fraction was of β Defensin, which is responsible for a wide variety of antimicrobial activity in various organisms. The consecutive peaks (13 kD and 19.7 kD), which were obtained may be because of the dimerization and trimerization of the peptide molecule.
Table 4: Mean of MIC values of Crude protein extract isolated from heart tissue of the Goat (CPH2) and the column isolated fractions (LVF2) against ten bacterial species
| S. No. | Bacteria | Clinical Isolate / MTCC Culture | MIC of recommended Antibiotic by CLSI | Crude Protein Heart CPH | Isolated Protein fraction of Heart LVF2 |
| Antimicrobial Peptide Identified | Heart Defensin | ||||
| 1. | Escherichia coli | MTCC Culture | Gentamycin 4 μg/ml | 250 μg/ml | 3.12 μg/ml |
| 2. | Enterococcus faecalis | MTCC Culture | Gentamycin 4 μg/ml | 31.25 μg/ml | 3.12 μg/ml |
| 3. | Pseudomonas aeruginosa | MTCC Culture | Gentamycin 4 μg/ml | 250 μg/ml | 6.25 μg/ml |
| 4. | Staphylococcus aureus | MTCC Culture | Gentamycin 4 μg/ml | 250 μg/ml | 3.12 μg/ml |
| 5. | Bacillus subtilis | MTCC Culture | Gentamycin 4 μg/ml | 250 μg/ml | 3.12 μg/ml |
| 6. | MRSA (Methicillin Resistant Staphylococcus aureus) | Clinical Isolate | Cefoxitine 4 μg/ml Mec A mediated Oxacillin Resis using Cefoxitine |
250 μg/ml | 12.5 μg/ml |
| 7. | MSSA (Methicillin sensitive Staphylococcus aureus) | Clinical Isolate | Cefoxitine 4 μg/ml Only Oxacillin Resis using Cefoxitine |
250 μg/ml | 12.5 μg/ml |
| 8. | ESBL (Extended spectru beta-lactam) | Clinical Isolate | Cefotaxime 4 μg/ml | 250 μg/ml | 12.5 μg/ml |
| 9. | Enterobacter hormaechei | Clinical Isolate | Ampicillin 8 μg/ml | 250 μg/ml | - |
| 10. | Enterobacter asburiae | Clinical Isolate | Ampicillin 8 μg/ml | 250 μg/ml | 6.25 μg/ml |
1-D SDS PAGE was also performed for LVF2 (fig. 3). Two bands were observed on polyacrymide gel, 1st at ~13 kD and another at ~19 kD. Further, proteins were eluted from the bands and were sent for mass spectrometry.

Fig. 4: Mass Spectrometric Data: Analyzed by Bioworks (a) m/z ratio of the purified fraction (b) molecular weight of the purified fraction
DISCUSSION
The clinical isolates selected for the present study are MRSA, MSSA, ESBL, E. hormaechei and E. asburiae which are found to be involved in a wide array of diseases. MRSA is believed to be the bacteria responsible for maximal nosocomial infection. The infection of MRSA can be either hospital acquired or community acquired, whereas MSSA are those which are sensitive to methicillin and oxacillin but resistant to other β – lactam antibiotic. ESBLs are extended spectrum beta lactamases which produces enzymes called β-lactamases that provides resistance to β-lactam antibiotics by destroying the structure of antibiotics. Normally E. coli belongs to this category[8]. Whereas, E. hormaechei and E. asburiae are strains, less reported, belongs to Enterobacteriaceae family that are found to be involved in causing secondary infections and sepsis. Both the strains have been hardly reported but can be associated with production of ESBLs which screws their treatment by limiting the therapeutic agents. E. hormaechei has been reported in a nosocomial outbreak at the California hospital with significant ESBL production[9].
According to our finding, the peptide isolated from the ventricle of heart tissue of Capra hircus showed its efficacy against bacteria, resistant or sensitive to certain antibiotics. The accurate molecular weight of the isolated peptide was deduced by the Applied Biowork system, which was found to be 6.5 KD. Later on, the partial sequence of amino acid was deduced and the homology was matched using the NCBI protein BLAST database. The partial amino acid sequence was found to be NHRSCHRIKGVCAPDRCPRXMXQU which shows homology to β Defensin of Capra hircus.
The mass spectrometry data analyzed by Bioworks also revealed that the three peaks obtained corresponds to 6.5 KD (monomeric), 13.0 KD (dimeric) and 19.7 KD (trimeric) molecular weights. Therefore finally concluding that oligomerization is possible in case of antimicrobial peptides which have hardly been reported. These AMPs are the components of the innate immune defence system but their expression is moderate to fight against high doses of infections. Cationicity, amphipathicity and ability to oligomerize are considered key factors for their action [10]. Upon interaction with negatively charged bacterial cell membrane dimerization or oligomerization of positively charged antimicrobial peptide will form a cleft like tail to insert them in lipid bilayer followed by hydrophobic interaction between peptide and lipid bilayer. Hoover et al. 2000 studied the x-ray structure of hBD2 which revealed unique secondary-structure element that helps in dimerization. A dimeric form of beta defensin was proved by light scattering experiments. It was suggested that the process of oligomerization continues until a stable and native octamer of defensin protein is achieved postulated to be the quaternary structure of hBD2 [11]. The present study concludes that the beta defensins are present in oligomeric forms which were confirmed by the spectral mass analysis. Such peptides are released under the stimuli from pathogens and can get upre gulated in case of severe infection. As the isolated peptide showed good response against antibiotic resistant bacteria so can be used as therapeutic agents for the upcoming era of antimicrobial resistance.
ACKNOWLEDGEMENT
The entire project was funded by ICMR (Indian Council of Medical Research, New Delhi, India). The authors are thankful to the ICMR, Department of Integrated Biotechnology, Ashok and Rita Patel Institute of Integrated Study and Research in Biotechnology and Allied Sciences, a CVM (Charutar Vidya Mandal) institute. We will also like to acknowledge SICART, Anand, for providing us the technical support and Shree Krishna Medical Hospital, Anand for providing us few antibiotic resistant bacterial strains.
ABBREVIATION
AMP: Antimicrobial Peptide, MS: Mass Spectrometry, SDS: Sodium Dodecyl Sulphate, PAGE: Polyacrylamide Gel Electrophoresis, ZOI: Zone Of Inhibition, MTCC: Microbial Type Culture Collection, MIC: Minimum Inhibitory Concentration, HBD: Human β-Defensin
CONFLICT OF INTERESTS
Declared None.
REFERENCES